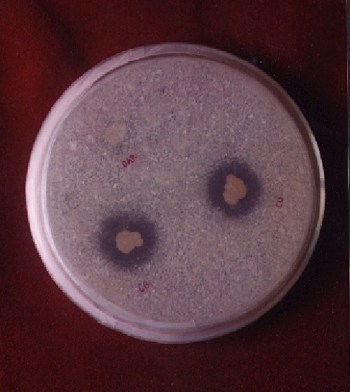
bakteri pelarut fosfat

Saya sering ditanya orang bagaimana membuat biofertilizer. Membuat biofertilizer sebenarnya gampang-gampang susah. Berikut ini sedikit rahasia bagaimana membuat biofertilizer berdasarkan pengalaman saya selama ini. Semoga tulisan singkat ini bermfantaat untuk Anda.
Membuat biofertilizer yang berkualitas tidaklah mudah dan murah. Penelitian intensif biofertilizer memerlukan biaya, waktu, dan tenaga tidak sedikit. Langkah-langkah yang saya sampaikan di bawah ini bukan merupakan langkah baku. Langkah-langkah ini bisa saja berbeda atau bisa saja dimodifikasi untuk mendapatkan hasil yang lebih baik. Mungkin juga setiap peneliti memiliki metode-nya masing-masing.Langkah-langkah utama membuat biofertilizer adalah sebagai berikut:
- Menentukan Mikroba Bahan Aktif
- Mengisolasi Mikroba Target
- Menyeleksi Mikroba Target
- Menentukan Metode dan Bahan Pembawa (carrier)
- Menentukan Metode Perbanyakan Secara Masal
- Membuat Prototipe
- Menguji Prototipe
- Pengujian Multi Komoditas, Multi Lokasi
Metode untuk mengisolasi, menguji dan menumbuhkan mikroba bahan aktif biofertilizer ada di dalam buku ini: Metode Analisis Mikroba Tanah
Menentukan Mikroba Bahan Aktif
Pertama adalah menentukan mikroba-mikroba apa yang akan digunakan sebagai bahan aktif biofertilizer. Pilihan yang biasa digunakan adalah mikroba penambat N, mikroba pelarut P, mikoriza, atau PGPR. Anda boleh saja berambisi untuk menggunakan semua kelompok mikroba. Tetapi untuk itu Anda juga perlu menyiapakn biaya-nya juga. Sejauh ini sangat jarang ada orang yang ahli di semua kelompok mikroba. Umumnya mereka fokus pada satu atau dua kelompok mikroba saja. Artinya, kalau Anda ingin mendapatkan semua kelompok mikroba, Anda juga harus mengumpulkan orang-orang yang ahli di bidangnya masing-masing. Cara yang lebih baik adalah bekerja dalam sebuah tim yang beranggotakan beberapa orang dengan keahliannya masing-masing. Pada tahap ini ditentukan juga tanaman targetnya, bisa untuk tanaman tertentu atau untuk beberapa tanaman. Pilih tanaman yang paling memiliki nilai strategis dan ekonomis. Jangan terlalu berambisi untuk membuat biofertilizer untuk semua jenis tanaman. Misalnya untuk tanaman kelapa sawit. Beberapa tahun lagi Indonesia menjadi produsen kelapa sawit no 1 di dunia. Adalah pilihan yang cukup beralasan jika anda ingin membuat biofertilizer khusus untuk kelapa sawit. Jika kita sudah menemukan satu biofertilizer untuk satu jenis tanaman, Anda bisa mencoba-coba untuk tanaman lainnya.
Gambar mikroskopik VAM /Mikoriza
Mengisolasi Mikroba Target
Langkah berikutnya adalah melakukan isolasi mikroba-mikroba target tersebut. Mikroba-mikroba umumnya diisolasi dari Rhizosphere atau daerah di sekitar perakaran. Untuk mikroba-mikroba yang bersimbiosis diisolasi dari akarnya langsung, seperti Rhizobium atau mikoriza. Atau mikroba yang hidup dipermukaan akar tanaman. Tanah-tanah sampel dikumpulkan dari berbagai tempat yang memiliki kondisi tanah, iklim, dan komoditas yang berbeda-beda. Tanah-tanah yang memiliki kondisi ekstrim bisa juga dipilih. Tidak jarang ditemukan mikroba yang efisien untuk sawit ditemukan dari tanah-tanah marjinal yang tidak ada tanaman kelapa sawitnya.
Setiap jenis mikroba memiliki metode isolasi sendiri-sendiri. Mentode ini sudah berkembang selama bertahun-tahun oleh para ahli. Misalnya untuk mikroba pelarut fosfat, medium yang sering digunakan adalah medium Pikovskaya. Tahap isolasi ini tujuannya adalah mendapatkan mikroba target sebanyak-banyaknya, baik dari jenis fungi, bakteri, atau aktinomicetes. Kegiatan ini bisa makan waktu lama sekali. Sering diulang-ulang dan untung-untungan hingga benar-benar mendapatkan mikroba yang diinginkan. Tahap ini juga banyak menghabiskan bahan. Tahap isolasi ini termasuk juga tahap pemurnian isolat yang diperoleh.
Mikroba palarut fosfat akan membentuk zona jernih pada medium Pikovskaya
Mikroba yang telah berhasil diisolasi kemudian diperbanyak, disimpan dan dipelihara. Jangan sampai isolat yang Anda peroleh mati, karena akan membuat semua biaya, tenaga, dan pikiran yang telah dikeluarkan jadi sia-sia. Penyimpanan yang agak sulit umumnya untuk mikroba-mikroba yang bersimbiosis dengan tanaman, apalagi obligat lebih repot lagi.
Menyeleksi Mikroba Target
Menyeleksi mikroba merupakan langkah yang sangat penting. Tujuannya adalah mendapatkan mikroba yang benar-benar unggul. Mikroba unggul adalah kunci dari kualitas biofertilizer yang ingin Anda buat. Banyak orang yang memproduksi biofertilizer, tetapi umumnya biasa-biasa saja. Kalau Anda memiliki mikroba yang jauh lebih baik dari mikroba yang mereka miliki, maka ini adalah modal Anda untuk mengalahkan mereka di pasaran. Seleksi juga sama sulitnya dengan mengisolasi mikroba. Waktu, tenaga, pikiran dan biaya yang dikeluarkan juga besar. Tapi jika berhasil, aku rasa akan setimpal dengan semua yang telah dikeluarkan.
Metode seleksi mikroba bermacam-macam, sama seperti metode isolasinya. Seleksi bisa dilakukan dalam beberapa tahap. Misalnya: 1) tahap laboratorium, 2) tahap rumah kaca, dan 3) uji coba skala lapang. Teknik seleksi biasanya diawali dengan seleksi kasar tujuannya untuk mendapatkan kandidat-kandidat mikroba unggul. Seleksi bisa dilakukan secara sederhana di dalam cawan petri, kemudian dilanjutkan dengan menggunakan erlenmeyer. Misalnya untuk mikroba penambat N, parameter yang digunakan adalah kemampuan untuk memfiksasi nitrogen. Sebagai langkah awal sebagai tolok ukur bisa menggunakan hasil yang pernah dilaporkan oleh orang lain. Pilih semua mikroba yang berada di atas batas itu. Kalau Anda tidak mendapatkkanya ulangi langkah sebelumnya, isolasi. Langkah ini bisa dilakukan berulang-ulang hingga mendapatkan mikroba yang benar-benar unggul.
Setelah seleksi di laboratorium dalam skala kecil selanjutnya adalah seleksi di rumah kaca. Kalau dalam seleksi sebelumnya yang diuji kemampuannya untuk memfiksasi nitrogen, melarutkan P, atau menghasilkan hormon, misalnya; maka langkah berikutnya adalah apakah benar mikroba itu bisa memberikan manfaat untuk tanaman. Seleksi masih dilakukan di rumah kaca yang kondisinya terkontrol. Di tahap ini tidak jarang mikroba yang unggul di cawan petri, tiba-tiba loyo di rumah kaca. Ibaratnya dia hanya ‘jago kandang’, ketika dilepas di ‘alam bebas’ mereka loyo. Tapi umumnya mikroba yang bagus di laboratorium, bagus juga di rumah kaca. Di sini juga dipilih beberapa mikroba. Jangan hanya pilih satu, karena belum tentu ini yang terbaik jika dilepas di ‘alam liar’.
Jika Anda ingin mengabungkan beberapa mikroba, baik untuk mikroba yang memiliki kemampuan sama (misal, sama-sama penambat N) maupun berbeda (penambat N + pelarut P), maka perlu dilakukan ujicoba kompatibilitas terelebih dahulu. Dua atau lebih mikroba diuji coba untuk menjawab pertanyaan apakah jika mikroba-mikroba tersebut akan memberikan pengaruh yang signifikan daripada jika mikroba-mikroba tersebut digunakan sendiri-sendiri. Pengujian bisa dilakukan di laboratorium maupun di rumah kaca.
Untuk lebih mudahnya saya berikan ilustrasi sebagai berikut, misalnya kita memiliki mikroba A dan B. Mikroba A secara signifikan dapat meningkatkan produksi hingga 20% dibanding kontrol. Demikian pula mikroba B secara signifikan dapat meningkatkan produksi hingga 25% dibanding kontrol. Belum tentu jika mikroba ini digabungkan maka hasilnya akan 20% + 25%. Bisa jadi akan tetap saja sama atau bahkan akan negatif hasilnya.
Ujicoba di rumah kaca juga sering dilakukan dalam bentuk prototipe mikroba yang telah disimpan dalam bawan pembawa Penjelasn tentang bahan pembawa saya uraikankan dibagian bawah. Seleksi berikutnya adalah seleksi di lapang. Seleksi di rumah kaca akan saya jelaskan nanti di bagian yang lain.
Proses seleksi ini harus dilakukan dengan sungguh-sungguh mengikuti kaidah-kaidah ilmiah dan menggunakan prosedur statistik yang benar. Kita harus benar-benar yakin, bahwa mikroba yang kita pilih adalah mikroba yang benar-benar unggul. Jika perlu dilakukan beberapa kali ujicoba untuk lebih menyakinkan. Kesalahan dalam seleksi akan membuat pekerjaan kita jadi sia-sia. Apalagi jika kita sudah melangkah cukup jauh.
Menentukan Metode dan Bahan Pembawa (carrier)
Pertanyaan berikutnya adalah bagaimana mikroba ini akan ‘dikemas’. Pilihan yang umum adalah dikemas dalam bentuk padat, serbuk, granul, pelet, tablet, atau cair. Saya belum pernah menemukan produk biofertilizer dalam bentuk gel. Banyak pertimbangan untuk menentukan dalam bentuk apa biofertilizer akan dikemas. Salah satunya adalah karakteristik dari mikroba tersebut. Sebagai contoh: ektomikoriza umumnya dibuat dalam bentuk padat, pelet, atau tablet; endomikoriza umumnya padat; biofertilizer berbahan aktif bakteri dan fungi bisa padat atau cair.
Metode pengemasan ini berkaitan erat dengan bahan pembawa apa yang akan digunakan. Saya tidak banyak memiliki pengalaman untuk biofertilzer dalam bentuk cair. Saya akan lebih banyak memberikan contoh untuk biofertilizer dalam bentuk padat. Formula bahan pembawa umumnya merupakan ‘rahasia perusahaan’. Kalau anda coba mencarinya di jurnal-jurnal ilmiah akan sangat jarang ditemukan. Pertanyaan kuncinya adalah membuat formula bahan pembawa yang bisa melindungi mikroba dalam waktu lama (>12 bulan), tetap memiliki viabilitas dan efektivitas tinggi. Ini bukan perkerjaan yang mudah.
Karena informasi dari sumber-sumber resmi sulit ditemukan, saya memiliki beberapa tip untuk Anda jika akan membuat formula bahan pembawa. Cara paling gampang adalah dengan mempelajari dari produk biofertilizer yang sudah ada di pasaran. Saya tidak menyarankan Anda untuk menjiplak mentah-mentah, tetapi belajar dari produk yang ada. Coba amati dan perkirakan kira-kira terbuat dari apa bahan pembawa itu. Memang biasanya ada semacam ‘resep rahasia’ yang sulit dideteksi, tapi ini merupakan awal yang sangat bagus untuk mulai. Umumnya bahan pembawa yang sering digunakan adalah bahan-bahan organik, mineral, atau liat. Bahan organik bisa tepung-tepungan: terigu, tapioka, maizena, sagu, atau tepung kompos, gambut, dll. Bahan mineral biasanya zeolit (biasa digunakan untuk mikoriza), gypsum, bentonit, kapur dan lainnya. Ada juga yang mengguanakan tanah liat tertentu, seperti untuk endomikoriza. Bahan-bahan ini bisa tunggal atau bisa juga merupakan campuran dari beberapa bahan. Ada juga yang memberikan tambahan nutrisi pada bahan pembawa tersebut.
Beberapa pertimbangan lain untuk memilih bahan pembawa adalah kemampuan dalam mempertahankan viabilitas dan efektivitas mikroba. Dan yang tak kalah penting adalah pertimbangan ekonomi. Mungkin saja bahan pembawanya sangat bagus, tetapi kalau harganya mahal jadi tidak bisa dijual. Setiap bahan juga memiliki keunggulan dan kelemahannya masing-masing. Misalnya bahan organik cukup bagus, tetapi bahan ini juga disukai oleh banyak organisme. Rasanya cukup sulit untuk mempertahankan kondisinya optimum dan terhindar dari kontaminasi.
Untuk menguji viabilitas biasanya diukur jumlah populasi mikroba dalam rentang waktu penyimpanan. Bisa setiap bulan, setiap tiga bulan hingga satu tahun lamanya. Waktu penyimpanan satu tahun sudah cukup bagus. Kemudian pengujian evektivias mikroba tersebut terhadap tanaman target.
Langkah membuat formulasi bahan pembawa ini bisa dilakukan sambil melakukan seleksi mikroba. Terutama jika sudah diketahui jenis mikrobanya. Jadi dilakukan secara pararel. Kalau Anda sudah sudah melakukannya akan terasa ‘asik’ dan menyenangkan. Tapi ada juga yang merasa bosan, karena waktu yang dibutuhkan sangat lama.
Menentukan Metode Perbanyakan Secara Masal
Setelah kita mendapatkan mikroba unggul dan bawah pembawa yang sesuai, langkah penting lainnya adalah mendapatkan metode berbanyakan mikroba secara massal. Pada tahap-tahap sebelumnya perbanyakan mikroba dilakukan dengan menggunakan bahan-bahan kimia sesaui dengan standard baku mikrobiologi. Bahan-bahan kimia ini harganya cukup mahal dan sangat tidak ekonomis jika digunakan untuk produksi massal. Oleh karena itu perlu dilakukan pula riset untuk memproduksi mikroba tersebut dalam skala besar.
Metode umum untuk memproduksi mikroba antara lain adalah fermentasi cair dan fermentasi padat. Bakteri dan aktinomycetes umumnya diproduksi dalam medium cair, sedangkan kapang dan jamur diproduksi dalam medium padat. Mikroba yang bersimbiosis dengan tanaman, seperti mikoriza, diproduksi bersama dengan tanaman inangnya. Pemilihan bahan media untuk memproduksi mikroba ini tergantung pada metode produksinya. Cobalah untuk menganti media bahan kimia dengan media dari bahan-bahan yang murah dan mudah didapat. Pekerjaan ini merupakan ‘seni’ tersendiri. Diperlukan kejelian dan ketekunan untuk mendapatkannya.
Selain media, kondisi kultur mikroba juga perlu diperhatikan. Misalkan apakah mikroba tersebut memerlukan aerasi atau bahkan perlu kondisi yang anaerob. Berapa suhu yang paling optimal untuk berkembang biak? Berapa waktu yang tepat untuk panen? Bagaimana cara pemanenannya? Dan pertanyaan-pertanyaan lain.
Salah satu pertimbangan untuk menentukan metode perbanyakan adalah pertimbangan ekonomi. Berapa biaya yang diperlukan untuk memproduksi 1 kg produk biofertilizer. Secara umum, jika Anda menggunakan banyak mikroba akan meningkat pula biaya produksinya.
Membuat Prototipe
Kalau sudah ketemu kandidat-kandidat mikroba bahan aktif dan bahan pembawanya, langkah berikutnya adalah membuat prototipe. Prototipe bisa terdiri dari beberapa contoh. Contoh-contoh ini mungkin sudah diseleksi dari beberapa percobaan dan dianggap sebagai hasil terbaik, misal: lima prototipe terbaik. Contoh biofertilizer dalam bentuk: cair, granul, serbuk, dan pelet. Atau bisa saja satu bentuk tetapi dengan beberapa formula, misal: cair A, cair B, cair C, dan seterusnya. Prototipe ini yang selanjutnya harus diuji dan dipilih mana prototipe yang akan menjadi produk akhir.
Menguji Prototipe
Pengujian prototipe pertama bisa dilakukan di rumah kaca dengan tanaman-tanaman target atau tanaman model. Jangan lupa untuk menggunakan prosedur statistik dengan benar dan teliti. Jika Anda ragu-ragu, ulangi lagi percobaan rumah kaca ini. Ingat Anda harus benar-benar yakin. Kadang-kadang peneliti bisa bias dalam analisa. Gunakan prosedur statistik sebagai alat untuk mengambil keputusan. Tapi jangan terlalu percaya statistik. Gunakan juga intuisi atau feeling atau firasat. Sekali lagi, hati-hati dengan keinginan yang bisa membiaskan hasil analisa Anda. Bedakan antara opini dan data. Fokus pada data-nya.
Ketika melakukan pengujian, amati pula tanamannya. Kalau anda dibantu oleh teknisi atau pembantu teknisi, jangan hanya lihat datanya saja. Sempatkan untuk melihat tanamannya. Bandingkan hasil analisa statistik dengan pengamatan Anda. Apakah ada yang janggal, ada yang berbeda, atau ada yang istimewa.
Dalam tahap ini, bisa saja sebuah prototipe diperbaiki. Sebagai contoh: pupuk organik bentuk serbuk memberikan hasil yang lebih baik dibandingkan bentuk granul. Tetapi masa simpannya lebih pendek daripada bentuk granul. Anda bisa melakukan modifikasi pada bentuk curah atau granulnya. Coba teliti lagi lebih seksama pada prototipe tersebut. Apakah granulnya terlalu keras, sehingga sulit hancur ketika berada di tanah dan akhirnya membuat efektifitasnya rendah. Langkah perbaikannya adalah membuat granul yang lebih mudah hancur.
Pengujian Multi Komoditas, Multi Lokasi
Apabila prototipe lolos dari pengujian di rumah kaca, langkah berikutnya adalah pengujian lapang. Pengujian bisa dilakukan di kebun percobaan, tetapi skalanya kecil. Kalau percobaan ini mendapatkan hasil yang konsisten, coba lagi di tempat yang lebih luas atau diulang di tempat yang berbeda-beda. Bisa juga Anda mencobanya dengan varietas yang berbeda, lokasi yang berbeda, cara budidaya yang berbeda, bahkan dengan komoditas yang berbeda. Ingat, gunakan prosedur statistik dengan benar dan teliti, tetapi jangan diperbudak oleh statistik.
Pada tahap ini sebenarnya bisa juga dilakukan pengujian pasar. Apakah calon konsumen mau menerima produk ini? Apakah cara atau metode penggunaanya bisa diterima oleh konsumen? Bagaimana dengan harga? Bagaimana dengan warna? Bagaimana dengan kemasannya? Bagaimana dengan ukuran kemasan? Bagaimana dengan nama? Dan lain-lain.
Bisa saja produk ini juga dicoba untuk mulai dijual. Dana yang diperoleh bisa digunakan untuk memperbaiki prototipe tersebut.
Kalau dari semua langkah ini berhasil, selamat Anda telah berhasil membuat BIOFERTILIZER.
Pengembangan Produk
Bukan berarti jika biofertilizer telah ditemukan Anda terus santai saja menikmati royalti. Tidak ada produk yang sempurna sekali jadi. Dalam perjalanan produk tersebut diperlukan perbaikan dan pengembangan. Anda tidak bisa diam saja. Teruslah berfikir dan mencari untuk membuat biofertilizer Anda lebih baik lagi.
Perbaikan bisa dilakukan dengan mempertimbangkan umpan balik dari pengguna. Dengarkan keluhan-keluhan pengguna. Dengarkan saran dan kritik dari pengguna. Perbaiki dan kembalikan lagi ke pengguna. Apakah ada pengguna bisa lebih menerima? Bagaimana umpan balik mereka?
Ternyata membuat biofertilizer tidak mudah ya…..!!!!
Download literatur gratis: Download di sini | Recomended site: Gudang Ebook Gratis

Untuk membuat biofert campuran, apa masing2 jenis mikroba perlu “diadu” alias diuji kecocokannya? Uji apa lagi yang diperlukan sehingga kultur campur efektif/sinergis anggota2nya? kalo boleh saya minta jurnal ttg campuran biofert fungi+bakteri dong… Trmkash pak
Ya…, kebetulan tulisan di atas belum selesai. Memang betul jika mau mengkombinasikan beberapa mikroba, salah satu langkahnya adalah harus diuji dulu kompatibiltasnya. Jika ngak cocok ya .. jangan dicampurkan atau dibuat sedemikian rupa agar mikroba-mikroba yang tidak kompatibel tidak saling mempengaruhi. Untuk jurnal bisa minta ke ibriec@indo.net.id ke bagian perpustakaan dengan Bu Magda, Bu siti rochmah, atau Bu Titi
hmmm…..susah g menguji sjauh mn isolat mampu memaksimalkan potensinya sebagai biofertilizer??trs kira-kira bahan atau media tanam apa yg cocok digunakan agar optimasi produknya dapat diketahui……bls scepatnya z pak…dtunggu
bisakah saya di beri informasi tentang kandungan apa saja yang ada di pelepah pisang
Mohon maaf, saya tidak tahu kandungan pada pelepah pisang.
isroi
dengan segala hormat
mas saya mau nanya dimana bisa beli biofertilizer..mohon informasinya
terimaksih
badrudin
081578737504
Pingback: HAMA DAN PENYAKIT TUMBUHAN UNSRI poenya masto2n :: Pupuk Organik, Pupuk Hayati, dan Pupuk Kimia :: April :: 2009
Pingback: Pupuk Organik, Pupuk Hayati, dan Pupuk Kimia « ISROI
bisa beli pupuk mikoriza.dimana tempatnya, saya mau beli yang jadi saja …….info kirim ke email dong…..
Hubungi kontak yang ada di link ini:
https://isroi.wordpress.com/promi/
Produk berbasis mikroriza namanya: SIMBIONRIZA dan MIKAZAE. Atau minta dihubungkan ke Dr. Happy Widiastuti.
Semoga bermanfaat.
BAKTERI NITROSOMONAS ITU APA?
BAGAIMANA CARA MENDAPATKANNYA?
Bakteri yang bisa merubah N menjadi nitrat. Coba tanyakan ke lab mikrobiologi fak pertanian UGM.
Mas Isroi,
bagaimana cara membuat pupuk organik cair dari limbah kambing tapi yang hasilnya tidak bau ? sy sudah coba cara yg dengan mencampur EM4 tapi hasilnya bau sekali … Terima kasih
Sepanjang pengetahuan saya semua pupuk organik cair yang dibuat dari kencing atau fermentasi herbal semuanya bau. Hanya sedikit pupuk organik cair yang baunya tidak menyengat. Setahu saja POC yang tidak bau karena bahannya memang tidak berbau menyengat.
Terima kasih pak atas informasinya. Webnya bagus, isi informasi bagus. Semoga terus dikembangkan
apakah pengertian dari biofertilizer, apa fungsi dan manfaat dari biofertilizer
Biofertilizer adalah pupuk hayati yg berbahan aktif mikroba. Pengertian dan manfaatnya coba cari2 diposting yg lain.
Biofertilizer adalah pupuk hayati yang berbahan aktif mikroba. Dilahkan cek di posting yang lain tentang biofertilizer. Gunakan fasilitas pencarian yang ada di kolom kiri blog ini.
kira-kira carrier spora mikoriza apa saja selain zeolit yang pernah lakukan.
Untuk endomikoriza setahu saya yang paling banyak dipakai adalah zeolit. kalau ektomikoriza ada yang pakai clay dan dibuat seperti tablet.
Siang Pak Isroi…..
Mohon informasi mengenai bio organik fertilizer, apa saja bahan baku yang dapat digunakan, karena saya belum melihat artikel mengenai bio organik. Terima kasih……….
siang pak,,
Mohon informasi untuk pembuatan pupuk organik yang bisa dipakai untuk budidaya lele,,termasuk pembuatan pakan organik,,apa saja bahan2 yang diperlukan dan bagaimana proses pembuatannya. Terimakasih pak,,,,
jika kita buat biofertilizer dgn campuran mikroba lebih dari satu jenis(banyak)itu lebih baik berupa granular atau berupa cair?
tergantung formulatornya. Ada yang buat dalam bentuk cair dan ada yang buat dalam bentuk granul. Yang tidak ada aturan umum mana yang lebih baik.
assalaualaikum, pak roi,
jika saya memperbanyak dari produk biofertilizer yang sudah ada dengan memberi media yang tepat dan nutrisi yang bagus apakah ini bisa juga bofertilizer jadi banyak ,sehingga nilai ekonomis bisa lebih murah lagi?
salam
dwi g s
Secara teoritis jawabannya ya. Namun prakteknya tdk selalu mudah.
Coba baca2 buku tentang dasar2 mikrobiologi, dasar2 mikrobiologi tanah, dan klo ada buku tentang produksi mikroba.
Pingback: Organic Fertilizer, Biofertilizer, and Chemical Fertilizer | Berbagi Tak Pernah Rugi
apa bedanya POC biofertilizer VS POC organik…? EM4 termasuk yang mana….?
POC singkatan dari Pupuk Organik Cair. Kalau POC organik saya tidak tahu maksudnya. Sedangkan biofertilizer adalah nama lain dari pupuk hayati yang isinya mikroba/makhluk hidup. EM4 singkatan dari (kalau tidak salah) Effective Microorganis 4, jadi termasuk biofertilizer cair. Maksudn saya EM4 produk dari Songgo langit. Kadang-kadang orang menyebut EM4 untuk produk-produk yang lain.
Sekitar Mei 2009 saya membuat pupuk organik cair yang mengandung mikroba dengan biang “Grow Quick” jenis Mix Plus. Bahan organiknya adalah kulit pisang, kulit pepaya, biji pepaya, buah-buahan busuk, ampas kopi susu, air cucian beras. Semua bahan padat dipotong kecil kemudian dibelender lalu direbus dalam panci Al dengan membakar kayu, tempurung kelapa, sabut kelapa, tandan kosong kelapa, pelepah kelapa, kertas, karton, dan kardus selama 4 jam, lalu dibiarkan dingin tapi dibiarkan di atas perapian itu. Kemudian setelah dingin dimasukkan kedalam botol bekas air minum isi ulang berkapasitas 19 l menggunakan corong, dimasukkan 200 ml biangnya, ditambahkan air yang telah direbus dan telah dingin hingga volume 15 l, mulut botol ditutup kelambu (supaya O2 masuk tapi serangga tidak boleh masuk) yang diikat erat dengan 2 karet gelang di leher botol, tidak diaduk (meminimalkan mikroba yang dorman terluka dan mati), dan disimpan di tempat gelap. Pada hari ke-3 dan seterusnya, botol diayun berputar sebanyak 60 putaran setiap hari. Pada hari ke-14 setelah diayun berputar 60 putaran, sekitar 1/3 cairan botol dituang ke ember, lalu botol disimpan kembali. Cairan disaring dengan saringan untuk kopi. Sebanyak 250 ml cairan itu dicampur air PDAM hingga volume 5 l di dalam semprotan bertekanan, lalu disemprotkan ke daun, batang, dan permukaan tanah tanaman. Aromanya cukup menyengat (tetangga sampai mengeluh) mirip sampah busuk dalam bak sampah di pasar tradisional, pernah juga mirip tahi kucing, padahal sebagusnya hampir tidak beraroma demikian atau beraroma mirip tanah. Hama serangga tidak terpengaruh, tanaman memang makin subur tapi malas berbuah padahal pernah berbuah. Maka cairan yang tidak dicampur air, saya ambil sedikit dengan sedotan plastik, lalu saya siramkan kepada gerombolan aphid di sehelai daun cabe merah. 2 hari kemudian terlihat gerombolan aphid mati demikian juga daun cabe (mungkin karena dehidrasi bukan pengaruh mikroba). Mas Isroi, mungkinkah karena aerasi kurang? Apakah mikrobanya memang efektif mengusir dan membasmi hama, efektif menyuburkan dan mendorong berbuahnya tanaman? Atau bagaimana? Spesies dan genus mikroba di label kemasan terlihat cukup lengkap, demikian juga unsur hara, asam humat, asam amino, hormon auksin, dan hormon gibberelin.
Mikoriza adalah kelompok fungi (jamur) yang bersimbiosis dengan tumbuhan tingkat tinggi (tumbuhan berpembuluh, Tracheophyta), khususnya pada sistem perakaran. Terdapat juga fungi yang bersimbiosis dengan fungi lainnya, tetapi sebutan mikoriza biasanya adalah untuk mereka yang menginfeksi akar.
termakasih infonya, visit blog dofollow saya juga ya gan ,
Apakah fungsi bakteri biofertilizer apabila disemprotkan ke daun?
bukankah bakteri biofertilizer itu bekerja di tanah?
bagaimanakah cara kerjanya apabila di daun dan apakah bakteri masih hidup dan berkembang biak?
Biofertilizer yg diambil dan aktif ditanah aplikasinya ke tanah bukan ke daun. Tapi ada juga beberapa mikroba yang memang hidupnya di daun dan aktif di daun. Mikroba ini diaplikasikan ke daun.
Klo mikroba tanah tapi diaplikasikan ke daun. Menurut saya tidak akan efektif.
mohon info, bagaimana ya cara peyimpanan bakteri dalam media cair yg sdh di biakan, ketika disimpan di jerigen dan ditutup rapat ko malah jerigennya menggelembung. terimakasih
Jerigen mengemlembung karena mikroba di dalamnya menghasilkan gas (CO2, O2 atau CH4). Mingkin pada waktu membuatnya ada banyak tambahan gula/karbohidrat atau protein yang bisa difermentasi oleh mikroba. Salah satu caranya, dibiarkan dulu sampai stabil baru dimasukkan ke jerigen/botol.
punten, saya punya beberapa isolat bakteri unggul. kepengen dibuat biofertilizer. apakah ada saran untuk carriernya?
Setiap mikroba mungkin memiliki karakteristik tertentu. Mesti coba-coba dulu sampai ketemu yang paling cocok.
Selama ini hanya bisa pakai Kartu Kredit. Pertamakali saya buatnya pakai VCC atau virtual credit card. Banyak yang jual di market place. Bisa dicoba.